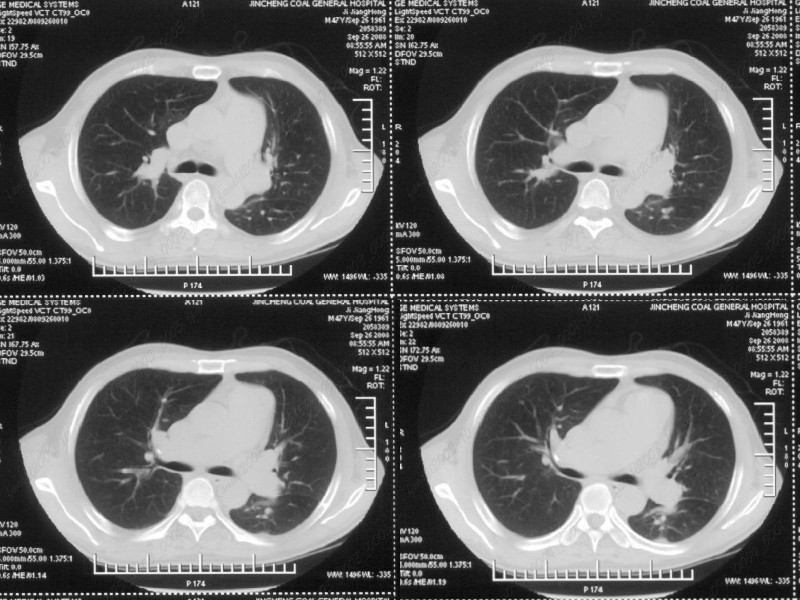

医影在线
标题: CT16366:【】男性,47岁。胸部不适一年,CT检查发现右胸膜下 [打印本页]
作者: fanshl 时间: 2008-10-28 15:59
标题: CT16366:【】男性,47岁。胸部不适一年,CT检查发现右胸膜下
男性,47岁。胸部不适一年,ct检查发现右胸膜下结节。http://www.radida.com/bbs/forum.php?mod=viewthread&tid=46094

[本贴已被 jiajie 于 2008-10-28 13:27:07 修改过]
[本贴已被 fanshl 于 2008-11-4 2:16:41 修改过]
[本贴已被 翁志蓬 于 2008-12-4 23:59:42 修改过]
作者: zsl6918 时间: 2008-10-28 16:12
标题: 1
图像很清,资料很全。工作做的很细,向您学习!观阁下的强化图像发现,您们强化后扫描时间挺早,延迟时间大约在16—18秒之间吧。估计目的是为了观察肺动脉及分支的情况。但现有的资料并不能提示动脉栓塞改变。建议楼主可在机器上仔细观察,或许会有异常发现。另外,个人感觉右侧应为肺内结节而非胸膜结节。考虑肺内良性小结节,炎性假瘤可能性大。
[本贴已被 jiajie 于 2008-10-28 13:28:55 修改过]
作者: 卜一 时间: 2008-10-28 16:29
右下肺前胸膜下小结节,强化不明显。建议定期观察!
作者: fanshl 时间: 2008-10-28 16:35
标题: 回复:男性,47岁。胸部不适一年,ct检查发现右胸膜下结
以下是引用zsl6918在2008-10-28 8:12:00的发言:[br]图像很清,资料很全。工作做的很细,向您学习!观阁下的强化图像发现,您们强化后扫描时间挺早,延迟时间大约在16—18秒之间吧。估计目的是为了观察肺动脉及分支的情况。但现有的资料并不能提示动脉栓塞改变。建议楼主可在机器上仔细观察,或许会有异常发现。另外,个人感觉右侧应为肺内结节而非胸膜结节。考虑肺内良性小结节,炎性假瘤可能性大。
胸膜下结节,就是肺内结节,不是么?
作者: 余辉 时间: 2008-10-28 16:39
标题: 1
病灶周围似有纤维化征像,增强明显强化,但中央可见点状低强化区,考虑慢性病变可能如炎性假瘤等,病灶边缘部分毛糙有切迹,双侧胸腔少量积液影,不除外恶性
[本贴已被 jiajie 于 2008-10-28 13:28:39 修改过]
作者: 深泽交通 时间: 2008-10-28 16:56
标题: 1
结节未见明显强化,局部胸膜增后粘连,内缘纹理影增重伴小围星灶,局部胸膜下小三角状实变影,尖端见纤维索牵扯征,综合考虑炎性病变,有增殖表现,不出外tb灶
[本贴已被 jiajie 于 2008-10-28 13:28:32 修改过]
作者: 随光逐影 时间: 2008-10-28 17:23
右肺中叶外侧段胸膜下结节状病灶,性质待定(不排除周围型肺癌可能)。
作者: fshk1 时间: 2008-10-28 18:48
考虑右下胸膜的炎性结节,
作者: 黑白光影 时间: 2008-10-28 18:54
右前胸膜下小结节,边缘有小纤维条索影与胸膜粘连,考虑如炎性假瘤之类慢性病变可能。期待二周后的结果。
作者: imageSS 时间: 2008-10-28 19:04
慢性炎症。
作者: luyan 时间: 2008-10-28 19:28
小结节的周围似乎与斜裂的走行有关,边缘分界不很清楚,与侧胸膜关系密切,有轻度强化,不能除外恶性,建议密切观察。
作者: sdzyy 时间: 2008-10-28 19:35
右下肺胸膜下小结节,强化不明显。建议定期观察!
作者: zjzjr 时间: 2008-10-28 19:36
标题: 回复:男性,47岁。胸部不适一年,ct检查发现右胸膜下结
以下是引用随光逐影在2008-10-28 9:23:00的发言:[br]右肺中叶外侧段胸膜下结节状病灶,性质待定(不排除周围型肺癌可能)。
作者: 358450m 时间: 2008-10-28 21:13
标题: 回复:男性,47岁。胸部不适一年,ct检查发现右胸膜下结
以下是引用zsl6918在2008-10-28 8:12:00的发言:[br]图像很清,资料很全。工作做的很细,向您学习!观阁下的强化图像发现,您们强化后扫描时间挺早,延迟时间大约在16—18秒之间吧。估计目的是为了观察肺动脉及分支的情况。但现有的资料并不能提示动脉栓塞改变。建议楼主可在机器上仔细观察,或许会有异常发现。另外,个人感觉右侧应为肺内结节而非胸膜结节。考虑肺内良性小结节,炎性假瘤可能性大。
作者: xulianj 时间: 2008-10-29 03:45
右肺中叶外侧段胸膜下结节状病灶,性质待定(不排除周围型肺癌可能)。
作者: fanshl 时间: 2008-11-4 10:14
汇报临床诊断:右肺动脉分枝栓塞
作者: zsl6918 时间: 2008-11-4 19:39
肺内小结节与肺动脉分支栓塞不一定有直接关系.
作者: 光影相伴 时间: 2008-11-4 20:23
标题: 回复:ct16366:男性,47岁。胸部不适一年,ct检查发现右胸
以下是引用zsl6918在2008-11-4 11:39:00的发言:[br]肺内小结节与肺动脉分支栓塞不一定有直接关系.
作者: yixianman001011 时间: 2008-11-6 01:06
考虑心脏疾患引起的右侧斜裂增厚。
作者: 深泽交通 时间: 2008-11-15 18:51
右肺静脉充盈缺损,左心房体积小,右肺动脉远端动脉充盈缺损,右肺血管影细小,考虑;右肺动脉远端栓塞.
作者: zhurui1113 时间: 2008-11-15 19:55
右肺中叶外侧段占位,考虑周围型肺癌伴局限性肺气肿,不除外炎性假瘤
作者: dr.yang 时间: 2012-5-4 07:17
右下肺前胸膜下小结节,强化不明显。建议定期观察!
欢迎光临 医影在线 (http://bbs.radida.com/bbs/) |
Powered by Discuz! X3.2 |